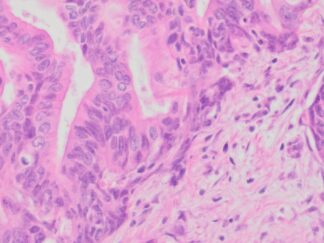

Human Colon & Rectum Cancer FFPE Sections
The human colon cancer FFPE sections are mounted on positively charged glass slides and sectioned at 5 µm thickness. These FFPE slides can be used to perform RNA scope ISH, FISH IF, IHC and NGS, etc.
Showing all 13 results
-

Human Colon Adenocarcinoma FFPE Sections
SKU: HuPS-07001T $139.99 -

Human Colon Mucinous Adenocarcinoma FFPE Sections
SKU: HuPS-07002T $139.99 -

Human Colon Adenocarcinoma FFPE Sections
SKU: HuPS-07003T $139.99 -

Human Colon Adenocarcinoma FFPE Sections
SKU: HuPS-07004T $139.99 -

Human Colon Adenocarcinoma FFPE Sections
SKU: HuPS-07005T $139.99 -

Human Colon Adenocarcinoma FFPE Sections
SKU: HuPS-07006T1 $139.99 -

Human Colon Adenocarcinoma FFPE Sections
SKU: HuPS-07006T2 $139.99 -

Human Colon Adenocarcinoma FFPE Sections
SKU: HuPS-07006T3 $139.99 -

Human Colon Adenocarcinoma FFPE Sections
SKU: HuPS-07006T4 $139.99 -

Human Colon Adenocarcinoma FFPE Sections
SKU: HuPS-07007T $139.99 -
Human Colon Moderately Differentiated Adenocarcinoma FFPE Sections
SKU: HuPS-07008T $139.99 -

Human Rectum Moderately Differentiated Adenocarcinoma FFPE Sections
SKU: HuPS-07009T $139.99 -

Human Rectum Moderately Differentiated Adenocarcinoma FFPE Sections
SKU: HuPS-07010T $139.99
Showing all 13 results
